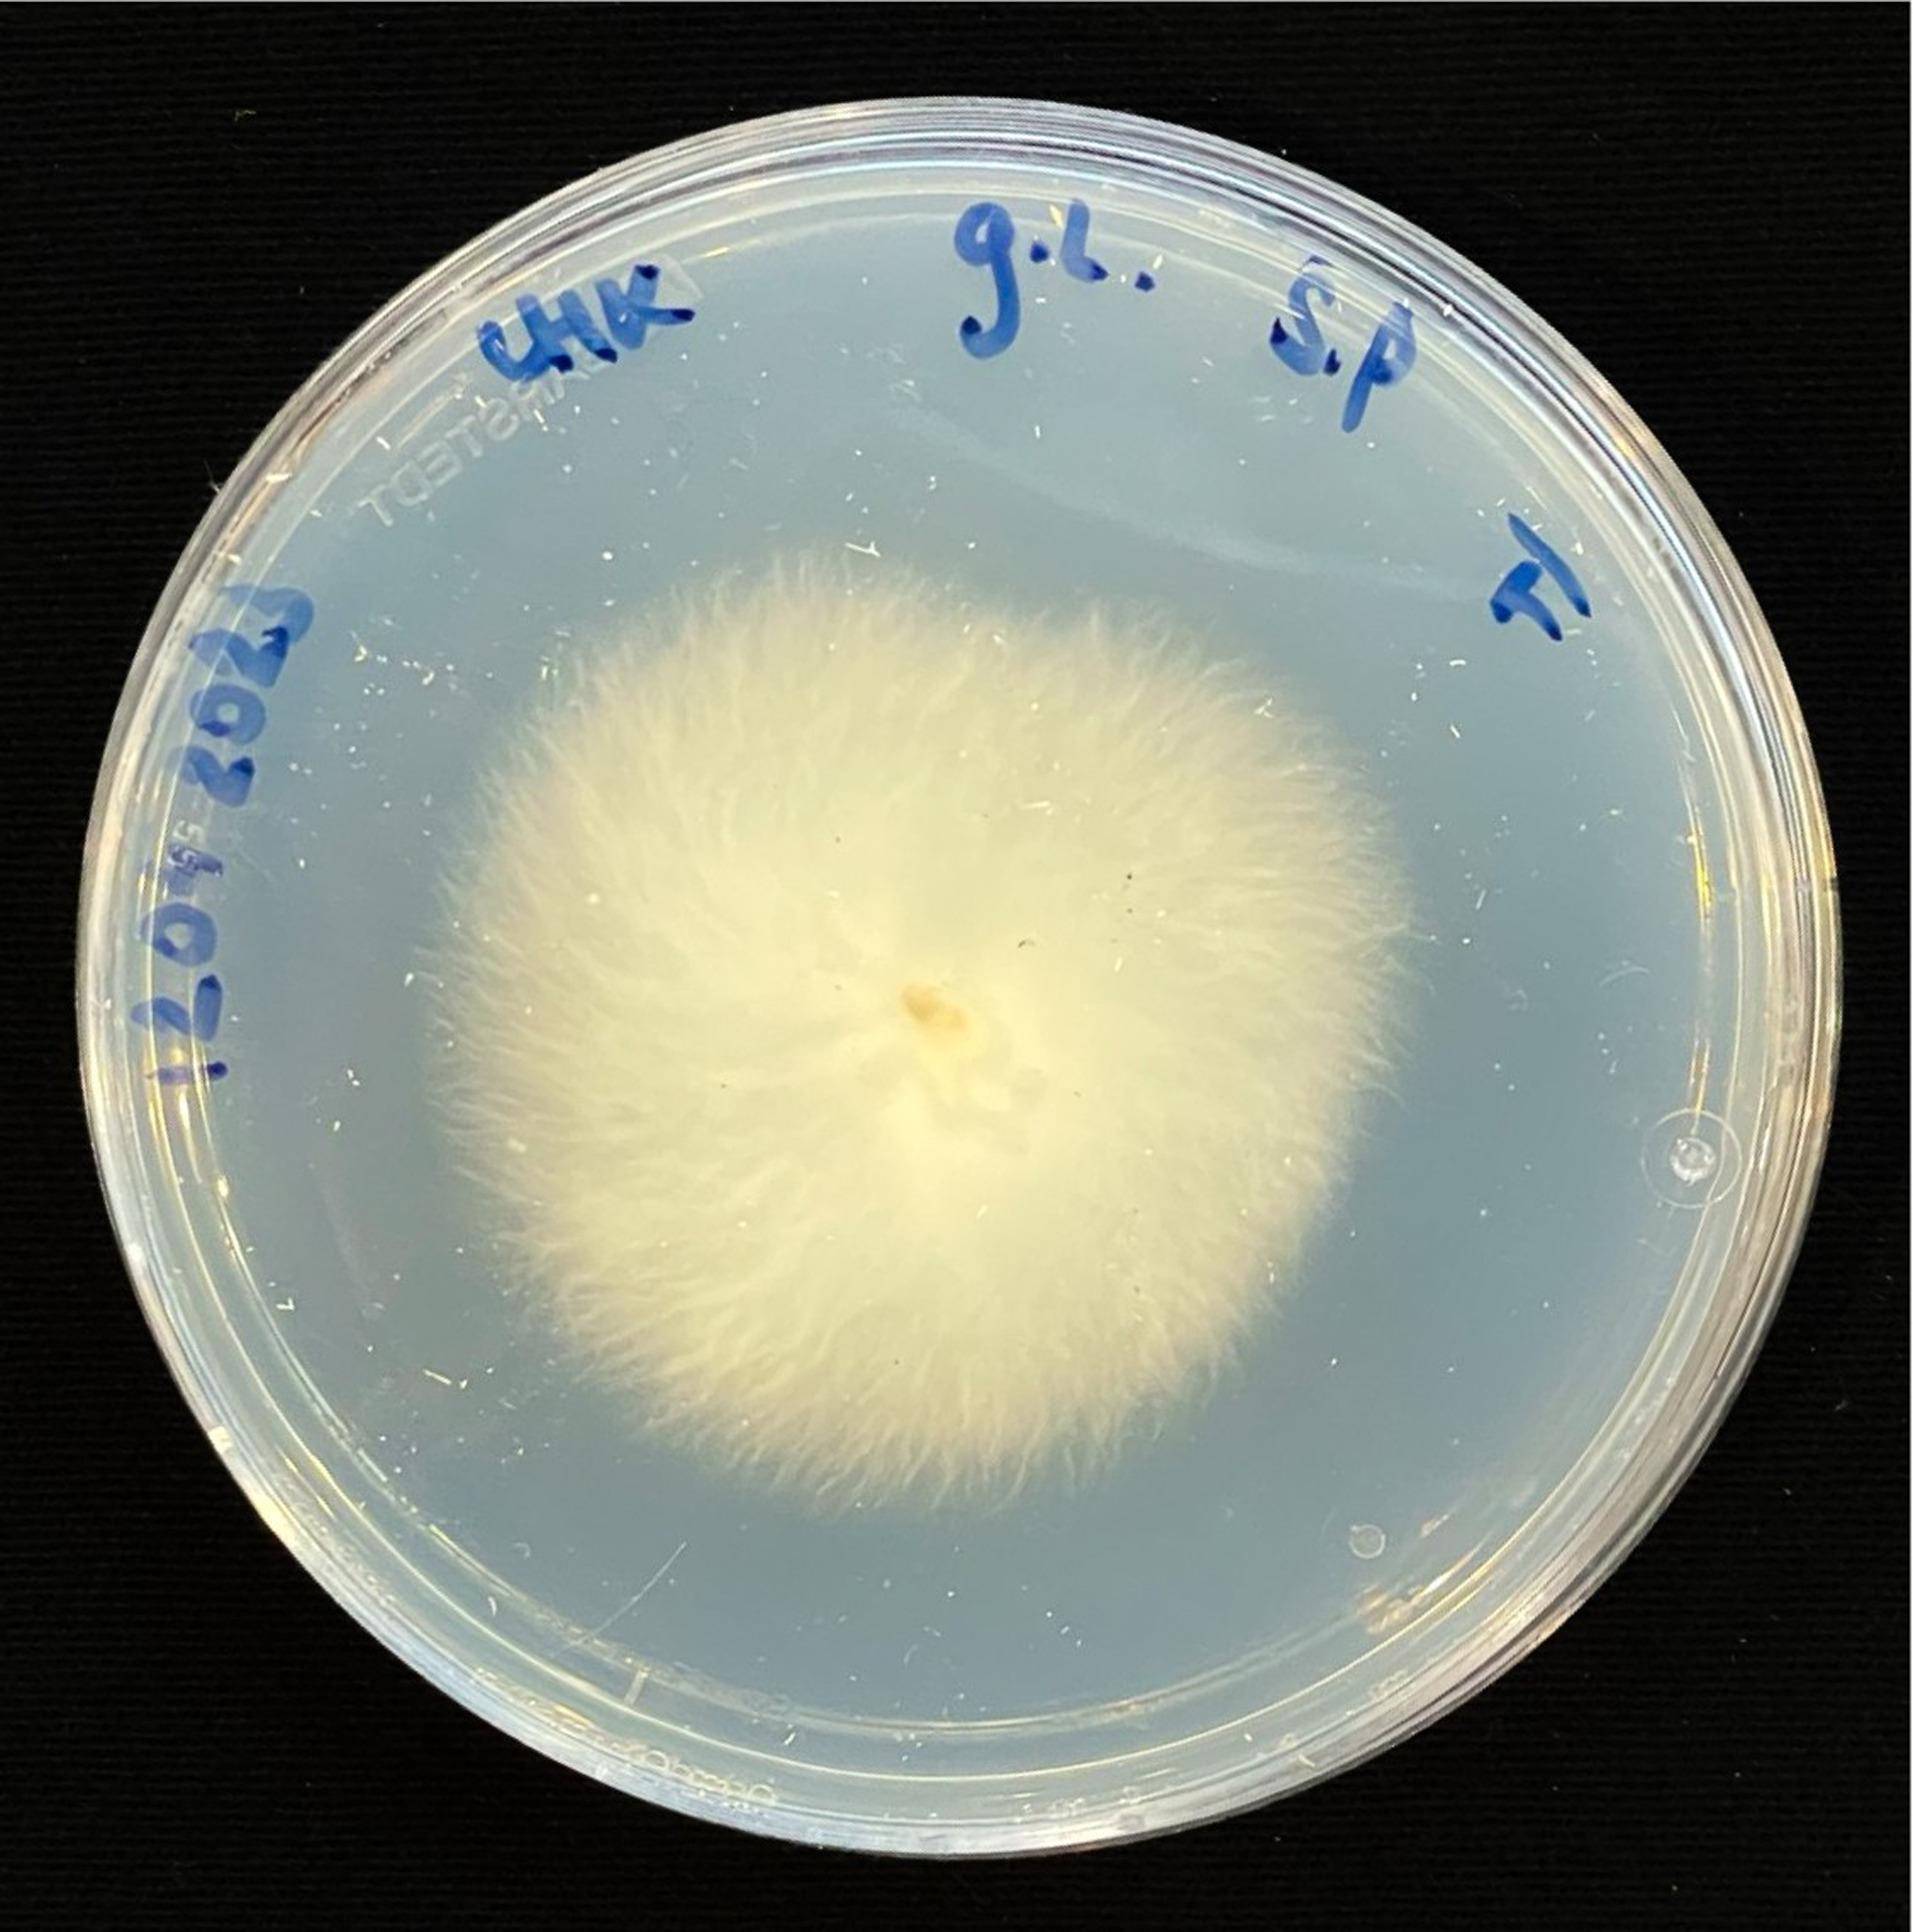
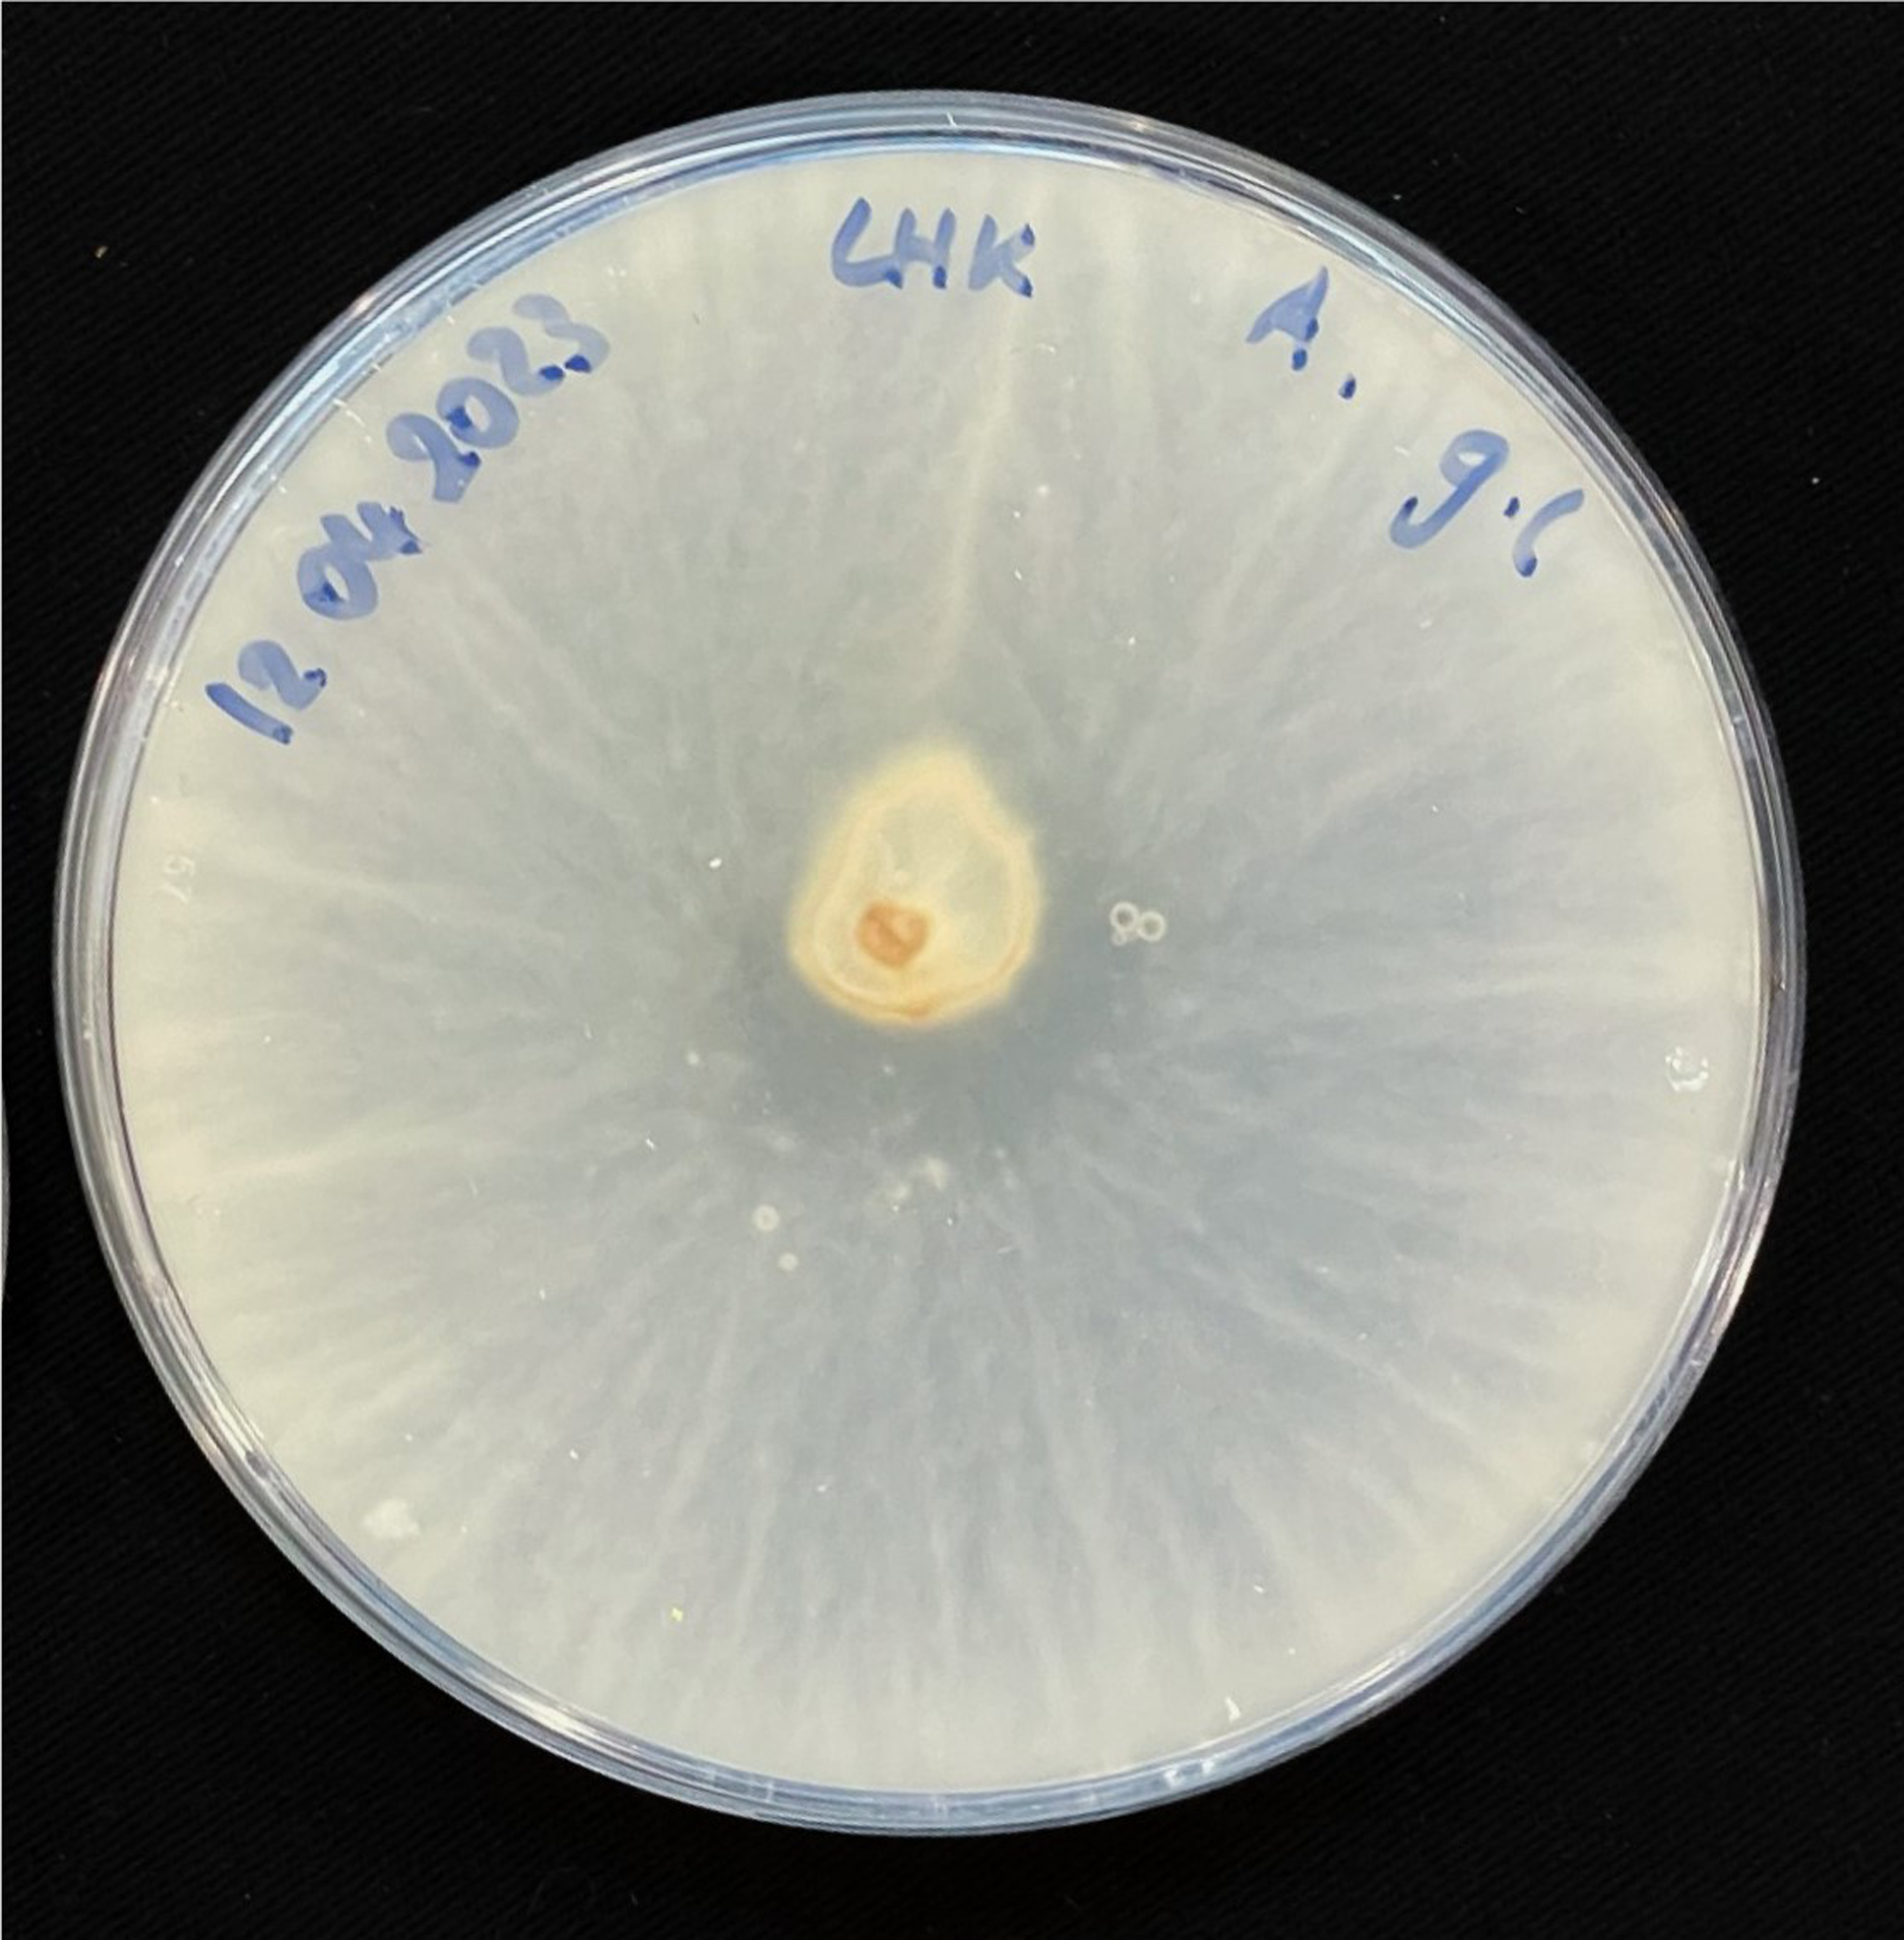
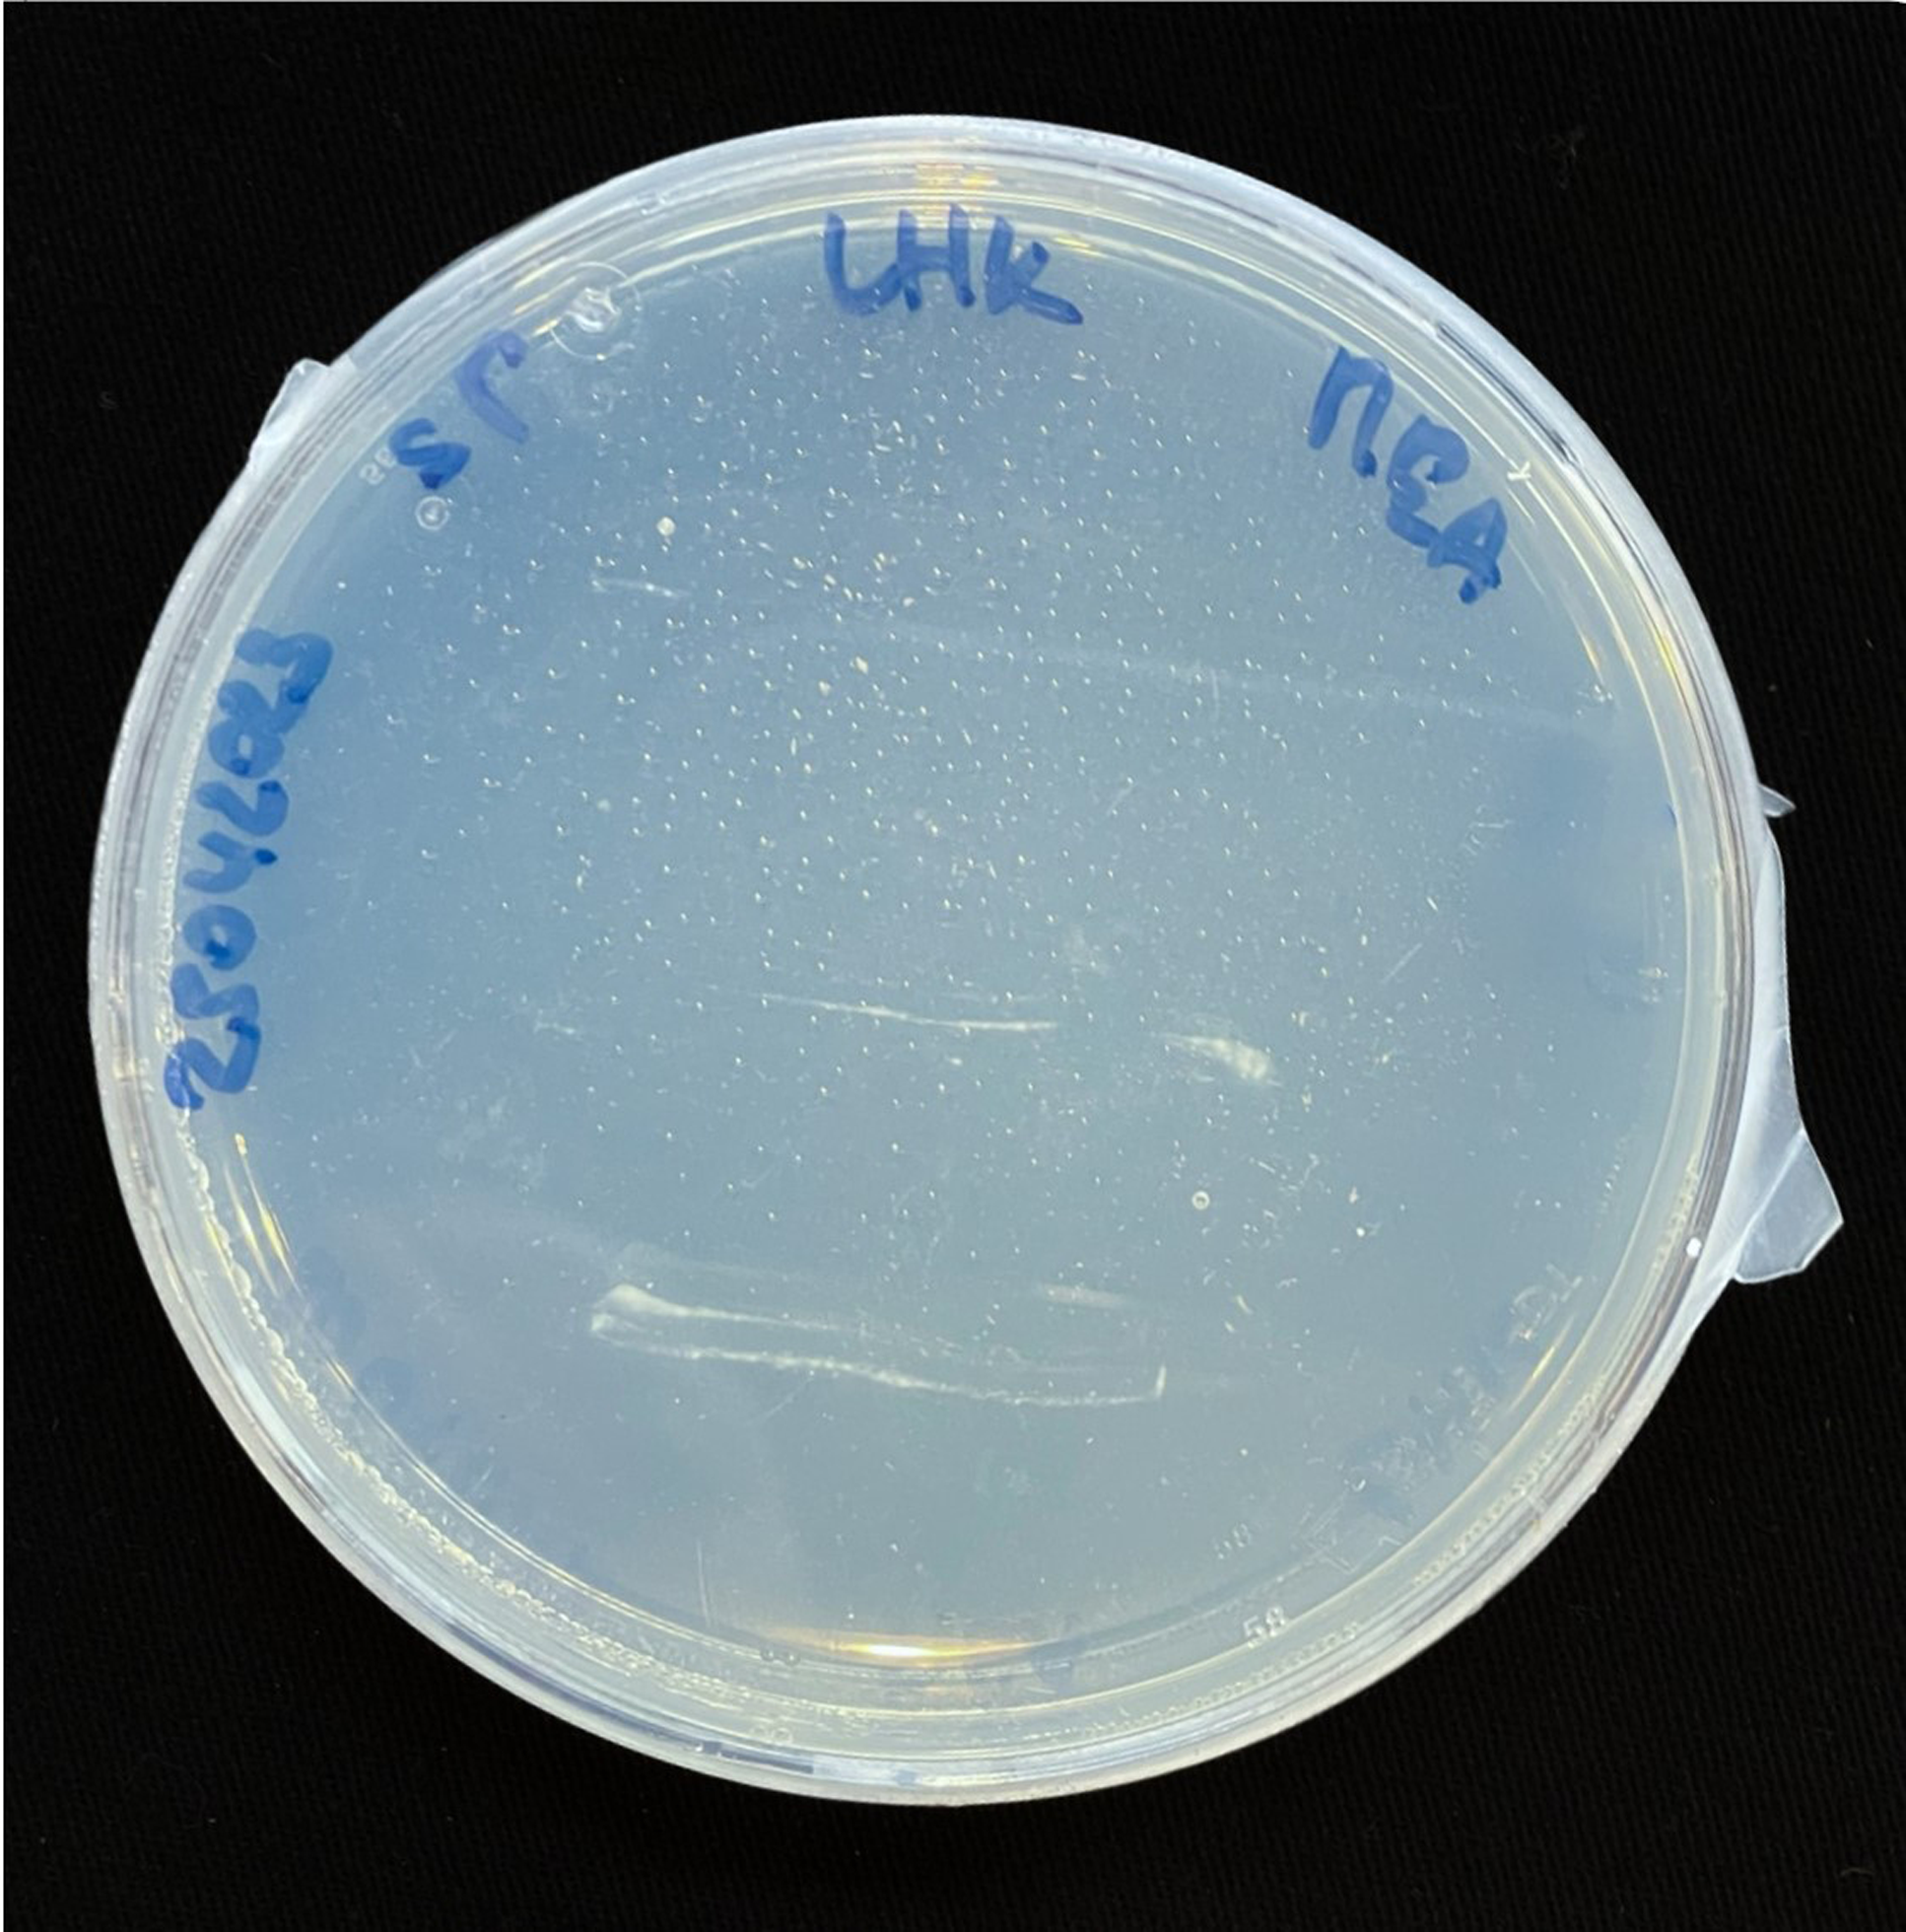

Introduction
Current standardized building methods and excessive use of planetary resources in the construction sector will eventually lead to raw material depletion. Furthermore, the current systems of gaining materials from a few highly desired natural resources are strongly linked to monocultures, loss of biodiversity, excessive consumption of energy and release of carbon into the atmosphere (Bitting et al., Reference Bitting, Derme, Lee, Van Mele, Dillenburger and Block2022; Livne et al., Reference Livne, Woesten, Pearlmutter and Gal2022; Ramsgaard Thomsen and Tamke, Reference Ramsgaard Thomsen and Tamke2022; Zhong, Schröder and Bekkering, Reference Zhong, Schröder and Bekkering2022). To relieve pressure from mostly extraction-based material origins, a shift toward diversification of material and adapted fabrication processes are unnegotiable. A push toward renewable and biodegradable materials (European Commission Expert Group, 2017) and linked biodesign strategies could offer one pathway toward a more sustainable building practice. Additionally, this shift has the potential to offer living environments to a diverse community of species. Being able to cope with living in heterogeneous environments, microbes as material forming and binding actors could further allow to readdress industrial or agricultural organic waste streams (Andréen and Goidea, Reference Andréen and Goidea2022).
This research specifically investigates the hosting of a poly-cultural microbial community, exploring if the co-hosting of these two species is feasible and if the sharing of space of the microbes contributes to the material composition through different characteristics and behavior. In this paper, early-stage research and experiments on the co-cultivation of the filamentous fungal strain Ganoderma lucidum and the calcium carbonate precipitating bacterial strain Sporosarcina pasteurii are described. It is an exploration of a multistep formation of a material coproduced and cohabited by these two species. While each microbial strain is contributing to material properties, this research further argues for a relationship as living partners, allowing the bacterial dispersal when in contact with the fungal partner and general influence on the living conditions of the other. The paper describes a series of qualitative experiments, which all describe the dispersal of the bacterial cells on the fungal hyphae as well as the effects of the co-cultivation gained as material binding qualities for architectural material use.
State of the art
Sporosarcina pasteurii
Sporosarcina pasteurii is one of the most used bacterial strains for microbially induced carbonate precipitation (MICP), due to its high production rate of the enzyme urease and related precipitation of calcium carbonate and no known pathogenicity (DSMZ, 1990; Omoregie, Reference Omoregie2020; Omoregie, Palombo and Nissom, Reference Omoregie, Palombo and Nissom2021). Additionally, S. pasteurii bacterial cells are motile and therefore capable of dispersing in liquid media. Biodesign strategies with this strain have been explored throughout fields of engineering, design and architecture investigating the potential to bind loose particles as sculpting or fixation techniques (Arnardottir et al., Reference Arnardottir, Dade-Robertson, Mitrani, Zhang and Christgen2020; Omoregie, Reference Omoregie2020) textile hardening (Beyer, Suárez and Palz, Reference Beyer, Suárez and Palz2019; Mosse, Suarez Zamora and Beyer, Reference Mosse, Suarez Zamora and Beyer2023) or glazing strategies eliminating energy-intense firing processes (Chrysikou, Reference Chrysikou2021). While MICP offers promising potential for the construction industry and industrial-scale stonelike material is already produced (Biomason, 2021), most research is based on complex nutrient media for the cultivation of the bacteria, which makes it economically unfeasible for industrial use (Lapierre et al., Reference Lapierre, Schmid, Ederer, Ihling, Buechs and Huber2020).
Ganoderma lucidum
Ganoderma is a globally distributed wood-decaying white-rod filamentous fungi genus, with a fast-developing and resilient mycelium, which can act as a binder to form lightweight composites (Loyd et al., Reference Loyd, Richter, Jusino, Truong, Smith, Blanchette and Smith2018). Mycelium-based composites (MBC) are ideal for shaping or growth in molds (Dessi-Olive, Reference Dessi-Olive2022) but have also raised interest in additive (Goidea, Floudas and Andréen, Reference Goidea, Floudas and Andréen2020) and subtractive manufacturing processes (Vanden Elsacker et al., Reference Vanden Elsacker, Søndergaard, Van Wylick, Peeters and De Laet2021). At the industrial scale, MBC are already on the market, for example, as acoustic panels (Mogu), thermal insulation (BIOHM) packaging and nonstructural building material (Ecovative). However, the mechanical properties of the foamlike material are still limited to non- or semi-structural applications in the construction industry (Jones et al., Reference Jones, Mautner, Luenco, Bismarck and John2020). Mechanical properties of MBC are highly linked to the substrate the fungi are inoculated into and can be improved by adding of inorganic particles or bacterial cellulose, however, a high percentage of inorganic particle content is also linked to reduced fungal growth (Elsacker et al., Reference Elsacker, Vandelook, Damsin, Van Wylick, Peeters and De Laet2021; Elsacker, De Laet and Peeters, Reference Elsacker, De Laet and Peeters2022).
Bacteria–fungi interaction
Bacteria–fungi interactions are described to account for nutrient cycling, symbiotic relationships, spatial accessibility and mobility through heterogeneous environments and as such to play an essential role in the functioning of nearly all ecosystems (Pion et al., Reference Pion, Spangenberg, Simon, Bindschedler, Flury, Chatelain, Bshary, Job and Junier2013; Deveau et al., Reference Deveau, Bonito, Uehling, Paoletti, Becker, Bindschedler, Hacquard, Hervé, Labbé, Lastovetsky, Mieszkin, Millet, Vajna, Junier, Bonfante, Krom, Olsson, van Elsas and Wick2018; Lohberger et al., Reference Lohberger, Spangenberg, Ventura, Bindschedler, Verrecchia, Bshary and Junier2019). In soil and other nonliquid habitats, some motile bacteria use the hyphal network to reach more favorable locations in it. This mode of cellular transportation is called fungal highways (FH) and is possible due to the living of the bacterial cells in the microhabitat surrounding the hyphae (Deveau et al., Reference Deveau, Bonito, Uehling, Paoletti, Becker, Bindschedler, Hacquard, Hervé, Labbé, Lastovetsky, Mieszkin, Millet, Vajna, Junier, Bonfante, Krom, Olsson, van Elsas and Wick2018).
Results
Experiment 1
Through microscopic analysis, using an optical microscope, it was determined that while bacterial cells were only added in the third and last area of the petri plate, and in some cases the substrate of the sections never touched prior to the mycelium bridging between them, all areas now contained bacterial cells (Figure 1), indicating the dispersal of bacterial cells through the composite. While no DNA sequencing tools were available to the research at that moment, a simple technique of adding a drop of a 1% CaCl2 solution to the slide was used. The immediate formation of CaCO3 minerals and the alikeness of the usually observed S. pasteurii cells indicated the presence of those in the sampled composite pieces.

Figure 1. S. pasteurii cells found within mycelium sample, light microscope 1000× magnification.
Experiment 2
The first set of three compositions was mixed as described in the method and had an upper layer of substrate that was not inoculated with either of the microbes. This experiment aims to determine if bacterial dispersal is linked to an interaction with the fungus and mixtures of chemical additives. In containers A and B, no bacterial cells or CaCO3 formation became visible when taking samples from the upper layer of substrate, where no microbes were inoculated into. In container C samples were taken at three positions. The first at the top of the substrate, where no mycelium growth was visible, in the middle, where mycelium had already reached from the bottom layer and from the lowest part of the container. At the top position, neither mycelium nor bacterial cells or CaCO3 occurred. At the middle position, many bacterial cells were visible, but with the drop of CaCl2, still no CaCO3 formed. In the last, bottom position of the container, which also contained urea, a high density of bacterial cells was visible, and upon adding the calcium source, CaCO3 formed.
In the second set, in D, bacterial cells were found in the samples of top and bottom container positions; however, no CaCO3 formed. In container E, a high density of bacterial cells, however, much smaller than compared to usual cultures in ideal nutrient media, were found. Again, no CaCO3 formation, however, in the lower part, where the bacterial cells were found in rod-shaped forms and in the usual size, CaCO3 formed upon adding the calcium source. In container F, again three samples were taken. The top position sample contained bacterial cells, and upon adding the solution of CaCl2 10%, no CaCO3 formed. Here, an additional test was introduced by adding a solution containing CaCl2 10% and urea 20%, which led to the appearance of CaCO3 minerals. The middle behaved the same as the previous and the lower position contained a high density of bacterial cells in different sizes and immediate CaCO3 formation upon adding of the CaCl2 10% solution.
Experiment 3
This experiment on microbial growth has revealed that while the bacterial partner thrives on its own on tryptic soy nutrient media with a concentration of 2% urea, they are not growing on malt extract agar (MEA) plates. However, when cohabiting those with the fungal partner, cells could be found in all sample places. This indicates that further than just a means of transport toward otherwise unreachable areas, the bacterial cells are also benefiting from the fungal presence for growth.
Experiment 4
This experiment investigated if MICP occurs throughout the composite or only on the extremities of the samples. Both series of biocementation tests were analyzed through microscopic imaging and revealed calcium carbonate formation throughout the composite. Differently structured CaCO3 formations were visibly attached to and in between the mycelium (Figure 2). The long fibers in the image are mycelium hyphae. Formations of different sizes of accumulation were found on the exterior (Figures 3 and 6) as well as on the interior (Figures 4 and 5) of the composite samples.

Figure 2. Different sized accumulations of CaCO3 in between and attached to mycelium, light microscope 1000× magnification.

Figure 3. Calcite formation on the exterior of an MBBC sample, magnification approx. 150×, digital microscope, after 5 days of cementation solution submersion and multiple days of drying.

Figure 4. Mycelium with bacterially precipitated CaCO3 formations, a sample from the exterior of MBBC sample, light microscope, 250× magnification.

Figure 5. Calcite formation on mycelium network interior of an MBBC sample, magnification approx. 800 with a digital microscope, after 5 days of cementation solution submersion and multiple days of drying.

Figure 6. CaCO3 formations on and around mycelium and wood substrate, light microscope, 1000× magnification.
After draining of liquid, microscopic imaging showed that bacterial cells were still present on the mycelium-bacteria-based composite (MBBC) and not flushed out. Additionally, even after drying of the samples after multiple days at room temperature, cells were still visible and moving around when resuspended in a liquid on a microscope slide. Currently, no data on living cell density is available.
Method
Work environment
The research presented in this paper has been executed using DIY versions of biolab essentials. Within this equipment, a heated orbital shaker and a laminar flow clean bench have been developed. Additionally, a reasonably inexpensive method to meet the need for sterile substrate and nutrient media can be found in a pressure cooker (DIY-biolab: Sterilisation, 2017), and a small temperature-controlled unit is used as an incubator to cultivate the microbial cultures. Different lab grades and more conventional nutrient media and conventional substrate options have been used for microbial cultivation. Additionally, while the general method of co-cultivation uses tap water, the initial experiments were produced using demineralized water.
Strains
S. pasteurii (strain DSM 33) has been ordered as a freeze-dried culture from the German Collection of Microorganisms and Cell-Cultures GmbH (DSMZ) and has been cultivated in the optimal conditions stated by the seller. 30 °C on Tryptic Soy Agar or in Tryptic Soy Broth (both purchased from Merck Danmark) on a heated orbital shaking table each nutrient medium containing 2% urea. Calcium carbonate (CaCO3) was precipitated by adding a cementation solution of 2% urea and 1% calcium chloride to the culture.
G. lucidum (strain M9726), which was initially received from Mycelia.be, but kindly shared by a researcher at the Royal Danish Academy, has been cultivated as mono-culture on MEA, rye berries soaked in tap water and beechwood sawdust at 27–29 °C in darkness. All media is rendered sterile through vapor sterilization in the pressure cooker reaching up to 118 °C for 60 minutes.
General exploration of co-cultivation method
In this research, one method of co-cultivation is based on the addition of CaCO3, precipitated by S. pasteurii, to the wood substrate, which is then inoculated with G. lucidum. For this, S. pasteurii was cultivated overnight, in liquid nutrient media using tryptic soy broth with 2% urea content at 30 °C in constant movement due to the orbital shaking table. A solution of 1% calcium chloride (CaCl2) was then added to the liquid media until the solution stopped turning cloudy white upon adding the calcium-rich solution. With the absence of a centrifuge in the lab, the liquid has been left to settle, and the CaCO3 is heavier than the nutrient media to accumulate in the bottom of the bottle. Then the liquid and the mineral substrate were separated by pouring off the excess liquid, and the wet substrate was laid out in an ajar petri dish for several days to air dry through water evaporation.
After growing for 5 days on an MEA petri plate and filling up toward the edges of the plate, G. lucidum was inoculated into tap water soaked and sterilized rye. For the rye mixture, whole grain, organic rye berries were soaked in lukewarm tap water for at least 6 hours and then vapor sterilized in an autoclavable bag with integrated micro-filters. The petri plate of G. lucidum is added to the room-temperature cooled bag of grains and inoculated at 28 °C in darkness for 5 days.
For further cultivation and growth of the composite, a beechwood sawdust was selected. This is an untreated sawdust, sourced from residual waste produced by industrial sawmills during timber production. The sawdust is then dried and sold as smoking wood for food production ( Dansktræmel ). The sawdust substrate was prepared with 70% volume/weight tap water and then vapor sterilized. After cooling down to room temperature, G. lucidum grown in the rye berries was inoculated together with different concentrations of the previously collected CaCO3, which was mixed into water. Through this method of mineral extraction, not only was CaCO3 collected from the liquid solution but also from bacterial cells of S. pasteurii. The sawdust mixture containing the co-cultivation was then incubated between 7 and 10 days at 28 °C and in darkness, and at the full covering of white mycelium of the composite and binding of the loose substrate, a piece of the composite was harvested and can be cultivated on MEA petri plates to continue the cycle of inoculation of sawdust (Figure 7).

Figure 7. Co-cultivation of G. lucidum and S. pasteurii.
Experiment 1 – Bacterial dispersal in composite through fungal interaction
The first experiment was executed in triplicate on small petri plates (5 cm diameter), each subdivided into discontinuous three areas containing different material compositions. The first third contains G. lucidum inoculated into beechwood substrate with 20% sterile, demineralized water to weight. In the second third, a 20% to weight ratio of the same liquid with 2% urea content was added. The third area contains a 20% to weight ratio liquid containing 2% urea and 10% precipitated CaCO3 powder. These substrate compositions were mixed in a separate container and added to each petri plate (Figure 8). After 9 days of inoculation at 28 °C in darkness, most of the substrate in the first two areas was covered in a white mycelium layer, while the third had a visibly lower mycelium growth (Figure 9).

Figure 8. Experiment 1 sections.

Figure 9. Left: Set up of dish with three areas; right: microbial growth after 9 days of inoculation.
Experiment 2 – Bacterial dispersal in composite through fungal interaction
A second experiment (Figure 10) aimed to reinforce the thesis of bacterial cell dispersal due to mycelial growth. For this, two sets of compositions were prepared. The first contained a top layer of sterile, wet wood, and the second set with a layer of sterile, wet wood was inoculated with GL. The lower parts were inoculated in different compositions with S. pasteurii, S. pasteurii with urea and S. pasteurii with urea and G. lucidum.

Figure 10. Experiment 2 composition.
Preparation Experiment 2
Beechwood sawdust with 70% weight/volume tap water was mixed and was vapor sterilized in an autoclavable bag. Of this, 2 g were added into each round plastic container of 3.5 cm diameter, resulting in about 0.5 cm material height. In each container, 20 µL of S. pasteurii overnight preculture, grown in TSB and 2% urea content, was added. Then 100 µL of urea 20% solution was added in four containers, and in two of those four, additional pieces of pre-grown G. lucidum wood composite were added.
The second layer of around 5 cm was added. The first set was simply filled with the same previously used beechwood sawdust. The second composition was premixed in an additional container, inoculating the sawdust again with pieces of pre-grown wood composite and filling each container to the same height.
All containers were incubated with closed individual lids at room temperature, around 21 °C, in darkness for 5 days. After the incubation time, the containers were individually examined for bacterial cells, using samples from the containers to observe under the light microscope and through adding 2 µL drops CaCl2 drops to the slides.
Experiment 3 – Microbial growth
For inoculation on agar plates, pieces of this MBBC have been sampled and placed in the center of MEA dishes and incubated at 28 °C in darkness (Figure 1). While the pure fungal inoculated petri dishes show much faster growth through covering of the plate (3–4 days), co-cultivation needs an extended incubation time to fully cover the plate (7–9 days) (Figures 11 and 12). The bacterial partner is usually cultivated on Tryptic Soy Agar dishes, containing 2% urea. When, however, plated onto MEA, in contrary to when in contact with mycelium, no bacterial growth occurs (Figure 13).
Figure 11. Four days after inoculation of GL and SP on MEA.
Figure 12. Four days after inoculation of GL on MEA.
Figure 13. SP inoculation on MEA.
Experiment 4 – MICP of microbial composite
This experiment explores the biocementation of the composite and contains two series of samples. The set examined pieces of 2.5 cm diameter at their largest length of MBBC inoculated into sawdust and activation of the biocementation process through submersion in cementation solution. This was repeated for 5 days where the cementation solution (as previously described in section “strains”) was changed every 24 h, therethrough adding more calcium source and producing more CaCO3. After emptying the liquids on the 5th day, the samples were dried at room temperature and in sterile conditions. The same process was executed for slightly larger cubes of 3 × 3 × 3 cm (Figure 14), giving the same results as previously.

Figure 14. 3 × 3 × 3 cm cubes of MBBC after biocementation and drying at room temperature.
Discussion
This research has shown that the bacterial partner, while not being able to translocate or extract nutrition and therefore unable to multiply in certain environments by themselves (here tested with wood substrate and MEA), can do so without the addition of nutrient media or suspension in liquid when cohabiting the environment with the fungal partner. Within this research, experiments of supplementing wood with nutrient media led to contamination through unwanted microbes due to its availability of nutrients. This unnecessity of a specific high-grade nutrient media for the bacterial partner renders the material formation through co-cultivated species less economically intense.
In the second experiment on bacterial cell dispersal through different aggregates and compositions of microbes and chemicals, it became apparent that bacterial cells were only found if they were in direct contact with G. lucidum. Additionally, larger cells were visible in direct presence to urea, and MICP was only possible when either urea was already present in the composite or added at the same time as the calcium source from the cementation solution. The translocation of the bacterial cells through the substrate when cohosted with the filamentous fungus is in the literature described by dispersal on the hyphae using the FH method, where motile cells move on the microscopic amount of water surrounding the hyphae (Simon et al., Reference Simon, Bindschedler, Job, Wick, Filippidou, Kooli, Verrecchia and Junier2015). The sharing of the environment by the bacterial and fungal partner here allows for rendering a form of nutrition available and translocation of the cells, which additionally eliminates the need for constant liquid suspension of the bacterial cells and bioreactors to aid bacterial growth.
As the bacterial partner moves through the substrate with the extension of the fungal network, a homogeneous distribution of the urease enzyme becomes possible and with it a homogeneous precipitation of CaCO3. This in return opens toward interesting perspectives for material formation at an architectural scale. As long as the fungal partner can grow and spread throughout the heterogeneous substrate, the bacteria can follow the established hyphal network and facilitate the precipitation of CaCO3. While this still needs to be examined at a larger scale, the process seems independent of scale. Additionally, biocementation of the fungal-bound composite could potentially lead to an increase of fire resistance as well as improving of the mechanical properties of the MBBC. While in previous research it was shown that fungal growth decreased when adding up to 5% of inorganic particles to the substrate (Elsacker, De Laet and Peeters, Reference Elsacker, De Laet and Peeters2022), in this research, the addition of mineral particles occurred after fungal growth and did not directly affect it. Furthermore, while these mechanical properties need to be numerically validated, a closer investigation of effects on the living through biomineralization activation as well as impacts in microbial interaction is necessary.
Furthermore, a controlled precipitation of CaCO3 could offer the possibility of selective, local activation, which in a material term could allow for local reinforcement of compressive strength. The current technique of submersion in a cementation solution shown in this paper results in more freely visible calcite on the outer surface of the cube, but homogeneous distribution within points toward even bacterial distribution. Future experiments to examine CaCO3 density and distribution throughout the composite. Similarly, data needs to be collected on CaCO3 precipitation in relation to calcium content in the cementation solution.
While this research has been executed in a DIY lab environment and without specialized tools, the research has run into certain limitations, such as more precise microscopic imaging and more controlled protocols with for example optical density analyzing tools. Additionally, while not described in the selected experiments, the lack of a certified flow clean bench has led to occasional contamination problems. However, not being able to use a highly equipped environment did not necessarily limit the research, as other methods could be applied in some cases, and in others, precision questions will need to be further evaluated. All experiments described in this paper are part of an early-phase research and have given results by reproducing most samples in triplicates and deducting the same behavior in all three replicates. However, these will need to be further examined and in the future lead to more standardized testing and fabrication protocols for the co-cultivation of the two selected species.
Conclusion
The experiments described in this paper are describing initial experiments, which are based on qualitative findings and need to be further studied for reproducibility of the experiments and more detailed results.
This paper has brought forward experiments of co-cultivation of a fungal and a bacterial partner for the binding and formation process of a material for architecture. Working with this community of microbes poses some intercommunity advantages and linked benefits for microbially produced materials, such as rendering available nutrients, mobility and accessing of space as well as equal distribution of bacterial cells throughout heterogeneous material. As the fungal network spreads, the bacterial cells can populate the space and homogeneously produce the urease enzyme, which is necessary for the precipitation of CaCO3. This finding can be further explored as a new method of adding inorganic particles into the MBBC, complementing research where particles are mixed into the composite before fungal inoculation as described by Elsacker et al. (Reference Elsacker, De Laet and Peeters2022) or precipitation of calcite by the fungal strain as brought forward by Van Wylick et al. (Reference Van Wylick, Monclaro, Elsacker, Vandelook, Rahier, De Laet, Cannella and Peeters2021). The material composite presented here opens discussions on methods of material formation, living materials in architecture, biowelding and mortar-less binding of elements. At the same time, questions of material as well as species locality, microbial collaboration and human–microbe interaction need to be considered in future explorations. Future explorations of this research will consider the mechanical behavior of the material and explore self-healing properties of such composites through the binding and filling with material in areas, where bacteria would usually not be able to reach on their own.
Data availability statement
The authors confirm that the data supporting the findings of this study are available within the article (and/or its supplementary materials).
Acknowledgments
This research is taking place with support from the Aarhus School of Architecture. Additionally, the author thanks Adrien Rigobello and the team at the Royal Danish Academy for the sharing of the fungal strain as well as offering support and instructions to cultivate it. Additionally, the author thanks Thora H. Arnardottir at New Castle University, Helene Skov Breum at Roskilde University and Fabian Steinacher at Aarhus University for their support to kick-start the research and create a DIY lab suitable to work with the bacterial strain.
Financial support
This research project is taking place with financial support and as a fully funded PhD fellow at the Aarhus School of Architecture.
Competing interests
None.
Ethics statement
No animal or human participants were part of this study; therefore, ethical approval was not needed from the school’s ethics committee.
Comments
No accompanying comment.